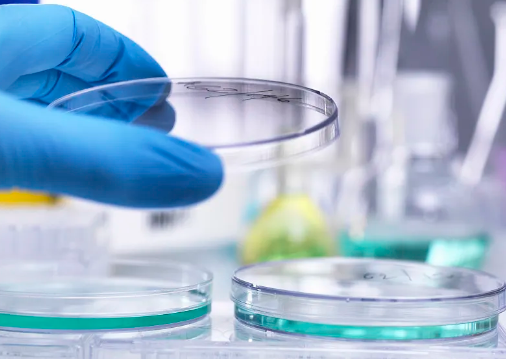
image.png

干細胞療法可以醫(yī)治哪些病效果如何
2024-08-16 15:09:47 來源: 小編 咨詢醫(yī)生
干細胞療法概述
干細胞療法是利用干細胞的再生能力,以修復或再生受損的組織或器官,并改善各種疾病癥狀的一種治療方法。干細胞可以分為胚胎干細胞和成人干細胞,前者具有更高的分化潛能,而后者在特定的組織修復中發(fā)揮關鍵作用。隨著生物醫(yī)學技術(shù)的發(fā)展,干細胞療法在多個領域顯示了良好的應用前景。
干細胞療法適用的疾病
1. 血液和免疫系統(tǒng)疾病
白血病:干細胞移植可以為白血病患者提供健康的造血系統(tǒng),有效延長生存期。
淋巴瘤:利用干細胞替代病變的淋巴細胞,改善患者的免疫狀態(tài)。
2. 神經(jīng)系統(tǒng)疾病
脊髓損傷:研究顯示,干細胞能夠促進神經(jīng)再生,改善功能恢復。
阿爾茨海默病:干細胞能夠替代受損的腦細胞,有助于改善記憶、學習能力。
3. 心血管疾病
心臟病:干細胞可用于修復心肌損傷,提高心臟功能,對急性心肌梗死的患者效果顯著。
心衰:通過干細胞治療,可以增強心臟的收縮力和改善血流動力學變化。
4. 骨關節(jié)疾病
骨關節(jié)炎:干細胞能夠促進軟骨再生,減輕疼痛并恢復關節(jié)功能。
骨折愈合:使用干細胞增強骨愈合過程,加速恢復。
5. 代謝和內(nèi)分泌疾病
1型糖尿病:干細胞療法致力于再生胰腺β細胞,有望改善胰島素分泌能力。
肥胖癥:通過干細胞調(diào)節(jié)脂肪代謝,促進體重控制。
干細胞療法的效果
干細胞療法的效果因患者的具體病情、干細胞類型及治療方式而異??傮w來說:
安全性:隨著技術(shù)進步,干細胞療法的安全性顯著提升,但依然存在一定的副作用,如感染、排斥反應等。
療效:許多臨床試驗顯示,干細胞療法在改善癥狀、功能恢復及生活質(zhì)量方面有良好的效果。然而,部分疾病仍處于實驗階段,實際臨床應用效果需要進一步驗證。
干細胞療法的未來發(fā)展
干細胞療法正在不斷發(fā)展,未來可能會應用于更多復雜和難治疾病領域??蒲腥藛T正致力于:
提高干細胞的獲取和擴增技術(shù):降低成本,提升治療的可及性。
優(yōu)化治療方案:研究個體化治療,根據(jù)患者的具體情況制定最佳治療方案。
探索新應用:將干細胞療法應用于更廣泛的疾病,如自身免疫疾病、退行性疾病等。
- 2024-09-16干細胞注射幾次效果好呢,干細胞治療療程和時間
- 2024-07-29存儲臍帶質(zhì)干細胞,存儲臍帶質(zhì)干細胞的作用
- 2024-10-21腦萎縮干細胞療法效果如何?哪種干細胞治療技術(shù)更先進?
- 2024-11-04瑞士干細胞治療優(yōu)勢有哪些?
- 2024-10-31國家推出干細胞療法了嗎?與傳統(tǒng)療法有何差異?
- 2024-10-26北京哪家干細胞療法醫(yī)院效果比較好?如何選擇專業(yè)可靠的干細胞醫(yī)院?
- 2024-08-06打一針干細胞要多少錢,打一針干細胞能管幾年
- 2024-08-18造血干細胞回輸全過程及注意事項
- 2024-09-04干細胞注射治療截癱效果如何多少錢
- 2024-09-17去泰國做干細胞機構(gòu)有哪些,附機構(gòu)名單
- 2024-09-22胚盤干細胞存儲機構(gòu)有哪些,內(nèi)附機構(gòu)名單
- 2024-09-15造血干細胞的基本特征,造血干細胞的三個特點
- 2024-09-14國內(nèi)牙髓干細胞存儲機構(gòu)名單匯總
- 2024-10-09干細胞填充嘴唇效果如何?全過程是怎樣的體驗?
- 2024-09-21干細胞抗衰老是真的嗎,帶你了解三大作用機理
- 2024-09-05干細胞移植治療腦梗塞效果好嗎,干細胞可以治療腦梗嗎
- 2024-08-20間充質(zhì)干細胞從哪里提取,提取全過程講解
- 2024-08-23脂溢性脫發(fā)干細胞療法有效果嗎
